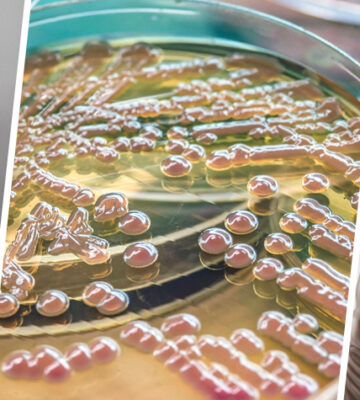

Agarose: Essential Polymer for Scientific Research Agarose is a versatile and widely used polysaccharide primarily derived from the cell walls ...
News
- Home
- News
Latest News
- By admin
- 0 Comments
Curdlan Gum – A Multifunctional Ingredient for Food, Pharmaceutical, and Cosmetic Applications
Curdlan Gum: A Multifunctional Ingredient for Food, Pharmaceutical, and Cosmetic Applications Curdlan gum is a natural polysaccharide produced by the ...
- By admin
- 0 Comments
Tara Gum – A Versatile Ingredient for Food, Pharmaceutical, and Cosmetic Applications
Tara Gum: A Versatile Ingredient for Food, Pharmaceutical, and Cosmetic Applications Tara gum is a natural polysaccharide derived from the ...
- By admin
- 0 Comments
Pharmaceutical and Cosmetic Grade Guar Gum
Pharmaceutical and Cosmetic Grade Guar Gum: A Versatile Ingredient for Modern Formulations In the constantly evolving fields of pharmaceuticals and ...
- By admin
- 0 Comments
Exploring Food-Grade Guar Gum
Exploring Food-Grade Guar Gum: A Key Ingredient in the Food Industry In the ever-evolving world of food science, the search ...
- By admin
- 0 Comments
Pharmaceutical and Cosmetic Grade Carrageenan
Pharmaceutical and Cosmetic Grade Carrageenan: A Versatile Ingredient for Modern Formulations Carrageenan, a natural polysaccharide derived from red seaweeds (primarily ...
- By admin
- 0 Comments
Understanding Food-Grade Carrageenan
Understanding Food-Grade Carrageenan: A Valuable Ingredient in the Food Industry At Seakol Bio Pharm, we are dedicated to providing high-quality, ...
- By admin
- 0 Comments
Agar-Agar – A Versatile Ingredient for Pharmaceuticals and Cosmetics
Agar-Agar: A Versatile Ingredient for Pharmaceuticals and Cosmetics At Seakol Bio Pharm, we recognize the growing demand for effective, natural ...
- By admin
- 0 Comments
The Versatility of Food-Grade Agar-Agar
The Versatility of Food-Grade Agar-Agar: Nature’s Gelatine Substitute At Seakol Bio Pharm, we pride ourselves on offering high-quality ingredients that ...
- By admin
- 0 Comments
Xanthan Gum – A Game-Changer in Pharmaceuticals and Cosmetics
Xanthan Gum: A Game-Changer in Pharmaceuticals and Cosmetics At Seakol Bio Pharm, we are dedicated to providing innovative and high-quality ...
- By admin
- 0 Comments
Unlocking the Potential of Food-Grade Xanthan Gum
Unlocking the Potential of Food-Grade Xanthan Gum: A Key Ingredient for Modern Culinary Innovation At Seakol Bio Pharm, we are ...
- By admin
- 0 Comments
Pectin in Pharma and Cosmetics
Pectin in Pharma and Cosmetics: The Natural Ingredient Transforming Product Formulations At Seakol Bio Pharm, we are dedicated to providing ...